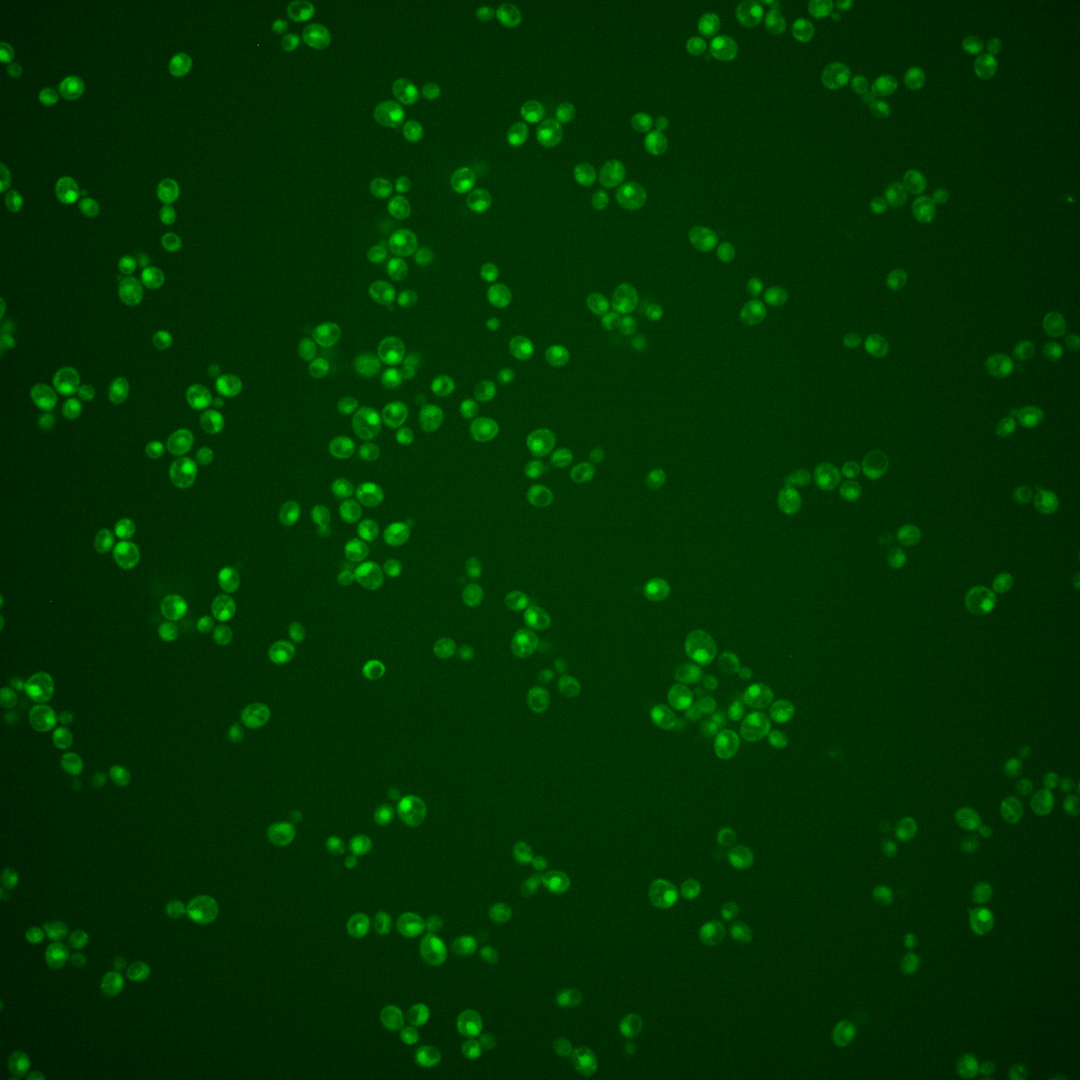
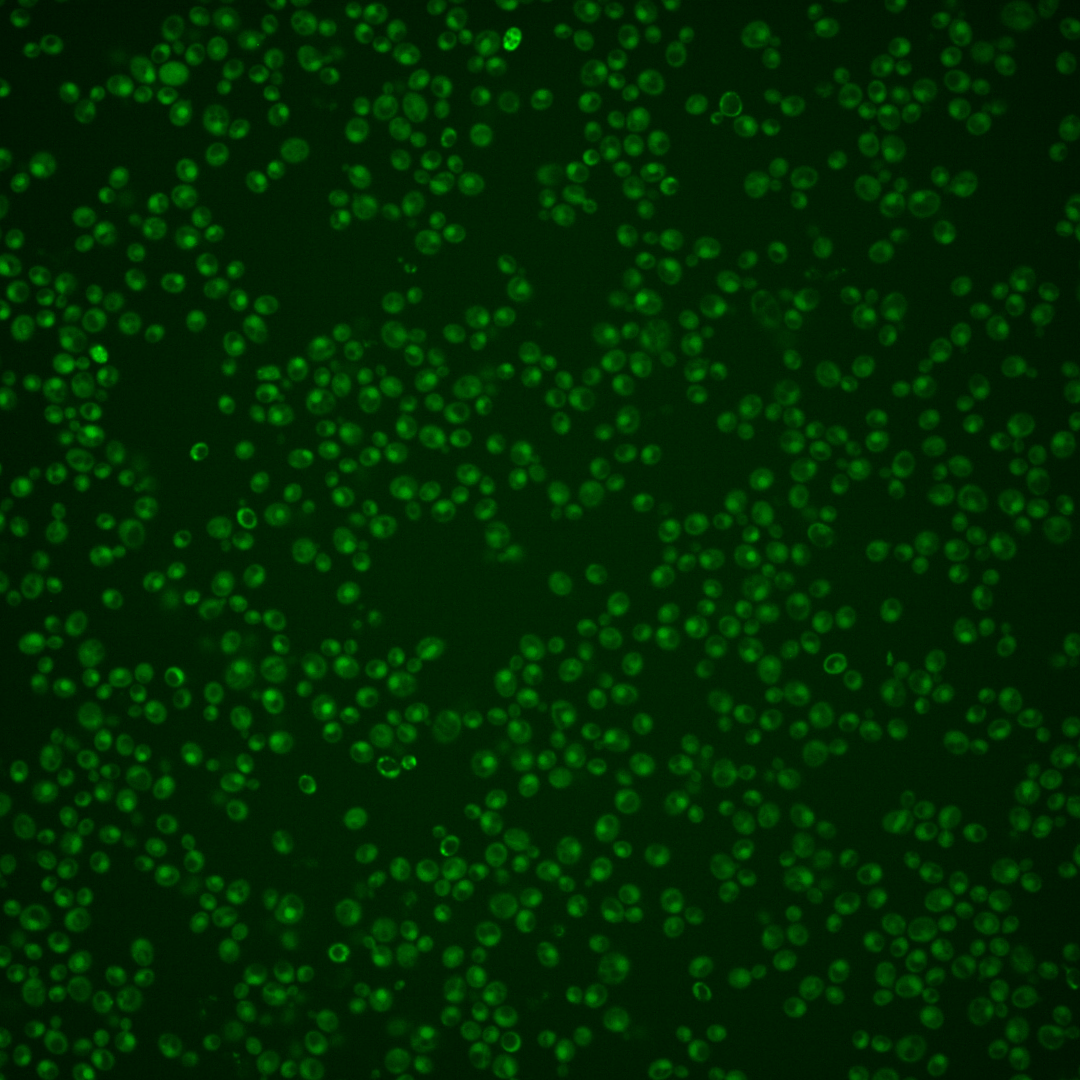

| Standard name | |
|---|---|
| Human Ortholog | |
| Description | AN1-type zinc finger protein, effector of proteotoxic stress response; stress-inducible transcriptional target of Rpn4p; induced by nitrogen limitation, weak acid, misfolded proteins; short-lived protein, degraded by proteasome; may protect cells from trivalent metalloid induced proteotoxicity; contains PACE promoter element; ortholog of human AIRAP, which stimulates proteasome activity in response to arsenic; protein abundance increases under DNA replication stress |
Micrographs




















































































Sub-cellular Localization
Yeast GFP Assignment
Protein Abundance
Localization Change
External localization resources
| ensLOC | DeepLoc | |||||||||||||||||||||||
|---|---|---|---|---|---|---|---|---|---|---|---|---|---|---|---|---|---|---|---|---|---|---|---|---|
| Localization | WT1 | WT2 | WT3 | RAP60 | RAP140 | RAP220 | RAP300 | RAP380 | RAP460 | RAP540 | RAP620 | RAP700 | HU80 | HU120 | HU160 | rpd3Δ_1 | rpd3Δ_2 | rpd3Δ_3 | WT1 | WT2 | WT3 | AF100 | AF140 | AF180 |
| Cortical Patches | 0 | 0 | 0 | 0 | 0 | 0 | 0 | 0 | 0 | 0 | 0 | 0 | 0 | 0 | 0 | 0 | 0 | 0 | 0 | 0 | 0 | 0 | 1 | 2 |
| Bud | 0 | 0 | 0 | 0 | 0 | 1 | 6 | 11 | 4 | 8 | 4 | 9 | 0 | 0 | 0 | 1 | 0 | 0 | 4 | 1 | 0 | 5 | 9 | 13 |
| Bud Neck | 0 | 0 | 0 | 0 | 0 | 0 | 0 | 1 | 0 | 2 | 0 | 0 | 0 | 0 | 0 | 0 | 0 | 0 | 0 | 0 | 0 | 0 | 1 | 1 |
| Bud Site | 0 | 0 | 0 | 0 | 0 | 4 | 3 | 2 | 8 | 10 | 4 | 5 | 1 | 0 | 0 | 0 | 0 | 0 | – | – | – | – | – | – |
| Cell Periphery | 0 | 0 | 0 | 0 | 0 | 0 | 0 | 0 | 0 | 1 | 0 | 0 | 0 | 0 | 0 | 0 | 0 | 0 | 0 | 0 | 0 | 0 | 0 | 0 |
| Cytoplasm | 27 | 3 | 14 | 12 | 20 | 31 | 44 | 98 | 56 | 116 | 96 | 156 | 36 | 82 | 138 | 23 | 18 | 17 | 16 | 1 | 10 | 9 | 13 | 7 |
| Endoplasmic Reticulum | 0 | 1 | 0 | 0 | 0 | 0 | 0 | 0 | 0 | 0 | 0 | 0 | 0 | 0 | 0 | 4 | 3 | 6 | 0 | 0 | 0 | 0 | 0 | 2 |
| Endosome | 0 | 0 | 0 | 0 | 1 | 0 | 2 | 1 | 0 | 0 | 0 | 1 | 2 | 1 | 2 | 5 | 2 | 1 | 2 | 0 | 0 | 2 | 4 | 2 |
| Golgi | 0 | 0 | 0 | 0 | 1 | 0 | 0 | 0 | 0 | 0 | 0 | 0 | 0 | 0 | 1 | 0 | 0 | 0 | 0 | 0 | 0 | 1 | 1 | 1 |
| Mitochondria | 53 | 3 | 32 | 64 | 20 | 140 | 306 | 322 | 269 | 340 | 393 | 444 | 15 | 9 | 6 | 4 | 2 | 3 | 1 | 0 | 2 | 1 | 6 | 3 |
| Nucleus | 308 | 51 | 17 | 112 | 191 | 174 | 287 | 211 | 95 | 128 | 139 | 117 | 381 | 332 | 284 | 71 | 55 | 76 | 323 | 67 | 43 | 159 | 295 | 276 |
| Nuclear Periphery | 0 | 0 | 0 | 1 | 0 | 4 | 7 | 6 | 4 | 1 | 4 | 4 | 0 | 0 | 0 | 0 | 0 | 1 | 0 | 0 | 0 | 0 | 0 | 1 |
| Nucleolus | 0 | 0 | 0 | 0 | 0 | 0 | 1 | 1 | 1 | 0 | 1 | 0 | 0 | 0 | 0 | 0 | 0 | 0 | 0 | 0 | 0 | 0 | 3 | 7 |
| Peroxisomes | 0 | 0 | 0 | 0 | 0 | 0 | 0 | 0 | 0 | 0 | 0 | 0 | 0 | 0 | 0 | 0 | 0 | 0 | 0 | 0 | 0 | 0 | 0 | 0 |
| SpindlePole | 0 | 0 | 0 | 0 | 0 | 0 | 0 | 0 | 0 | 1 | 2 | 1 | 0 | 0 | 0 | 0 | 1 | 0 | 6 | 0 | 1 | 5 | 8 | 6 |
| Vac/Vac Membrane | 48 | 11 | 1 | 11 | 14 | 23 | 56 | 41 | 32 | 31 | 30 | 38 | 50 | 88 | 137 | 38 | 34 | 36 | 54 | 11 | 18 | 29 | 58 | 93 |
| Unique Cell Count | 372 | 65 | 51 | 151 | 230 | 261 | 500 | 519 | 334 | 476 | 490 | 583 | 447 | 477 | 510 | 128 | 100 | 121 | 414 | 84 | 81 | 216 | 409 | 426 |
| Labelled Cell Count | 436 | 69 | 64 | 200 | 247 | 377 | 712 | 694 | 469 | 638 | 673 | 775 | 485 | 512 | 568 | 146 | 115 | 140 | 414 | 84 | 81 | 216 | 409 | 426 |
Yeast GFP Assignment
Protein Abundance
| Screen | WT1 | WT2 | WT3 | RAP60 | RAP140 | RAP220 | RAP300 | RAP380 | RAP460 | RAP540 | RAP620 | RAP700 | HU80 | HU120 | HU160 | rpd3Δ_1 | rpd3Δ_2 | rpd3Δ_3 | AF100 | AF140 | AF180 |
|---|---|---|---|---|---|---|---|---|---|---|---|---|---|---|---|---|---|---|---|---|---|
| Mean Cell GFP Intensity (1e-4) | 4.4 | 5.0 | 3.3 | 4.4 | 5.4 | 4.1 | 3.6 | 3.5 | 2.9 | 3.2 | 2.9 | 2.9 | 5.6 | 5.8 | 5.6 | 8.9 | 9.2 | 8.9 | 5.2 | 6.1 | 6.4 |
| Std Deviation (1e-4) | 0.6 | 0.7 | 0.7 | 1.6 | 1.4 | 1.6 | 1.1 | 0.9 | 0.8 | 1.0 | 1.2 | 1.0 | 1.0 | 1.3 | 1.2 | 3.0 | 3.2 | 3.8 | 1.3 | 1.5 | 1.5 |
| Intensity Change (Log2) | – | – | – | 0.42 | 0.72 | 0.33 | 0.12 | 0.08 | -0.18 | -0.06 | -0.18 | -0.2 | 0.76 | 0.83 | 0.78 | 1.45 | 1.49 | 1.44 | 0.66 | 0.9 | 0.96 |
Localization Change
| Localization | RAP60 | RAP140 | RAP220 | RAP300 | RAP380 | RAP460 | RAP540 | RAP620 | RAP700 | HU80 | HU120 | HU160 | rpd3Δ_1 | rpd3Δ_2 | rpd3Δ_3 |
|---|---|---|---|---|---|---|---|---|---|---|---|---|---|---|---|
| Cortical Patches | 0 | 0 | 0 | 0 | 0 | 0 | 0 | 0 | 0 | 0 | 0 | 0 | 0 | 0 | 0 |
| Bud | 0 | 0 | 0 | 0 | 0 | 0 | 0 | 0 | 0 | 0 | 0 | 0 | 0 | 0 | 0 |
| Bud Neck | 0 | 0 | 0 | 0 | 0 | 0 | 0 | 0 | 0 | 0 | 0 | 0 | 0 | 0 | 0 |
| Bud Site | 0 | 0 | 0 | 0 | 0 | 0 | 0 | 0 | 0 | 0 | 0 | 0 | 0 | 0 | 0 |
| Cell Periphery | 0 | 0 | 0 | 0 | 0 | 0 | 0 | 0 | 0 | 0 | 0 | 0 | 0 | 0 | 0 |
| Cytoplasm | -3.6 | -3.7 | -2.9 | -4.1 | -1.5 | -1.8 | -0.5 | -1.3 | -0.1 | -4.4 | -1.8 | -0.1 | -1.4 | -1.3 | -2.1 |
| Endoplasmic Reticulum | 0 | 0 | 0 | 0 | 0 | 0 | 0 | 0 | 0 | 0 | 0 | 0 | 0 | 0 | 0 |
| Endosome | 0 | 0 | 0 | 0 | 0 | 0 | 0 | 0 | 0 | 0 | 0 | 0 | 0 | 0 | 0 |
| Golgi | 0 | 0 | 0 | 0 | 0 | 0 | 0 | 0 | 0 | 0 | 0 | 0 | 0 | 0 | 0 |
| Mitochondria | 0 | -9.0 | 0 | 0 | 0 | 0 | 0 | 0 | 0 | 0 | 0 | 0 | -9.0 | -8.5 | -9.0 |
| Nucleus | 5.2 | 7.3 | 4.5 | 3.3 | 1.0 | -0.7 | -1.0 | -0.7 | -2.2 | 8.8 | 5.2 | 3.1 | 2.7 | 2.5 | 3.5 |
| Nuclear Periphery | 0 | 0 | 0 | 0 | 0 | 0 | 0 | 0 | 0 | 0 | 0 | 0 | 0 | 0 | 0 |
| Nucleolus | 0 | 0 | 0 | 0 | 0 | 0 | 0 | 0 | 0 | 0 | 0 | 0 | 0 | 0 | 0 |
| Peroxisomes | 0 | 0 | 0 | 0 | 0 | 0 | 0 | 0 | 0 | 0 | 0 | 0 | 0 | 0 | 0 |
| SpindlePole | 0 | 0 | 0 | 0 | 0 | 0 | 0 | 0 | 0 | 0 | 0 | 0 | 0 | 0 | 0 |
| Vacuole | 0 | 0 | 0 | 2.1 | 0 | 0 | 0 | 0 | 0 | 2.1 | 3.0 | 3.9 | 4.1 | 4.4 | 4.1 |
External localization resources
Images






























Protein Concentration and Protein Localization Data
| R1 | R2 | R3 | ||||||||||||||||
|---|---|---|---|---|---|---|---|---|---|---|---|---|---|---|---|---|---|---|
| G1 Pre-START | G1 Post-START | S/G2 | Metaphase | Anaphase | Telophase | G1 Pre-START | G1 Post-START | S/G2 | Metaphase | Anaphase | Telophase | G1 Pre-START | G1 Post-START | S/G2 | Metaphase | Anaphase | Telophase | |
| Concentration | 0.742 | 1.6189 | 1.2146 | 1.0878 | 0.7577 | 1.1142 | 0.8349 | 1.4031 | 1.0989 | 0.8476 | 1.3564 | 1.2049 | 2.058 | 2.7595 | 2.2363 | 2.3788 | 1.8911 | 2.4609 |
| Actin | 0.01 | 0 | 0.0019 | 0 | 0.0035 | 0.0011 | 0.0334 | 0.0003 | 0.002 | 0 | 0.0007 | 0.0014 | 0.0181 | 0.0001 | 0.0052 | 0.0142 | 0.0352 | 0.0009 |
| Bud | 0.0002 | 0 | 0 | 0 | 0.0006 | 0.0001 | 0.0006 | 0 | 0.0005 | 0 | 0 | 0.0003 | 0.0002 | 0 | 0.0001 | 0.0006 | 0.0001 | 0.0001 |
| Bud Neck | 0.0004 | 0.0001 | 0.0001 | 0.0002 | 0.0005 | 0.0018 | 0.0014 | 0.0001 | 0.0003 | 0.0001 | 0.0009 | 0.0049 | 0.0015 | 0.0001 | 0.0001 | 0.0044 | 0.0004 | 0.0034 |
| Bud Periphery | 0.0008 | 0 | 0 | 0 | 0.0047 | 0.0001 | 0.0006 | 0 | 0.0007 | 0 | 0.0001 | 0.0009 | 0.0002 | 0 | 0.0001 | 0.0014 | 0.0003 | 0.0001 |
| Bud Site | 0.0003 | 0 | 0.0001 | 0 | 0.0007 | 0.0001 | 0.0046 | 0.0001 | 0.004 | 0 | 0.0001 | 0.0011 | 0.0006 | 0.0001 | 0.0001 | 0.0019 | 0.0005 | 0.0001 |
| Cell Periphery | 0.0001 | 0 | 0 | 0 | 0.0003 | 0 | 0.0002 | 0 | 0.0001 | 0 | 0 | 0.0002 | 0.0001 | 0 | 0 | 0.0002 | 0.0001 | 0 |
| Cytoplasm | 0.0093 | 0.0077 | 0.0075 | 0.0004 | 0.0077 | 0.0085 | 0.0248 | 0.0189 | 0.0084 | 0.0011 | 0.0018 | 0.0029 | 0.0121 | 0.0189 | 0.0132 | 0.001 | 0.0019 | 0.0064 |
| Cytoplasmic Foci | 0.0057 | 0 | 0.0031 | 0 | 0.0023 | 0.0004 | 0.0235 | 0.0008 | 0.0112 | 0 | 0.0023 | 0.0019 | 0.0097 | 0.0002 | 0.0006 | 0.0019 | 0.0054 | 0.0003 |
| Eisosomes | 0.0001 | 0 | 0 | 0 | 0.0001 | 0 | 0.0005 | 0 | 0 | 0 | 0 | 0 | 0.0002 | 0 | 0 | 0.0002 | 0.0005 | 0 |
| Endoplasmic Reticulum | 0.0012 | 0.0003 | 0.0002 | 0 | 0.0083 | 0.0007 | 0.0042 | 0.0029 | 0.0002 | 0.0001 | 0.0007 | 0.0004 | 0.0019 | 0.001 | 0.0003 | 0.0009 | 0.0006 | 0.0006 |
| Endosome | 0.0037 | 0.0001 | 0.0012 | 0 | 0.0362 | 0.0022 | 0.0434 | 0.0036 | 0.0055 | 0 | 0.0126 | 0.0041 | 0.0099 | 0.001 | 0.0004 | 0.0087 | 0.0073 | 0.0009 |
| Golgi | 0.0019 | 0 | 0.0008 | 0 | 0.0032 | 0.0006 | 0.0166 | 0.0002 | 0.0042 | 0 | 0.0051 | 0.002 | 0.0032 | 0 | 0.0005 | 0.0034 | 0.0053 | 0.0001 |
| Lipid Particles | 0.0086 | 0 | 0.0038 | 0 | 0.0088 | 0.0016 | 0.0199 | 0.0002 | 0.005 | 0 | 0.034 | 0.0029 | 0.0063 | 0 | 0.0003 | 0.0062 | 0.0207 | 0 |
| Mitochondria | 0.0104 | 0.0002 | 0.0004 | 0.0001 | 0.0191 | 0.0007 | 0.0113 | 0.0002 | 0.0046 | 0.0001 | 0.0016 | 0.0083 | 0.001 | 0.0004 | 0.0003 | 0.0096 | 0.0027 | 0.0002 |
| None | 0.0045 | 0.0056 | 0.0095 | 0 | 0.0016 | 0.0066 | 0.0101 | 0.0066 | 0.0083 | 0.0001 | 0.0003 | 0.0007 | 0.0154 | 0.0034 | 0.0223 | 0.0011 | 0.002 | 0.0101 |
| Nuclear Periphery | 0.0197 | 0.0299 | 0.0096 | 0.0009 | 0.0378 | 0.0234 | 0.0212 | 0.0179 | 0.0088 | 0.0047 | 0.0095 | 0.0111 | 0.0121 | 0.015 | 0.0069 | 0.0086 | 0.0089 | 0.0055 |
| Nucleolus | 0.0035 | 0.002 | 0.002 | 0.0029 | 0.005 | 0.0065 | 0.0039 | 0.0022 | 0.0018 | 0.0013 | 0.0418 | 0.0131 | 0.0061 | 0.0019 | 0.0021 | 0.0042 | 0.0042 | 0.0044 |
| Nucleus | 0.8944 | 0.9518 | 0.9546 | 0.9948 | 0.8484 | 0.9351 | 0.7426 | 0.9358 | 0.9271 | 0.9915 | 0.8819 | 0.9316 | 0.8821 | 0.953 | 0.9432 | 0.9171 | 0.8848 | 0.9621 |
| Peroxisomes | 0.0121 | 0 | 0.0033 | 0 | 0.0004 | 0.0002 | 0.0199 | 0 | 0.0047 | 0 | 0.0015 | 0.0014 | 0.0087 | 0 | 0.0014 | 0.003 | 0.0059 | 0 |
| Punctate Nuclear | 0.0107 | 0.0012 | 0.0016 | 0.0005 | 0.0014 | 0.0087 | 0.0124 | 0.0091 | 0.0014 | 0.0008 | 0.0035 | 0.0062 | 0.0095 | 0.002 | 0.0023 | 0.0093 | 0.0121 | 0.0043 |
| Vacuole | 0.0015 | 0.0004 | 0.0002 | 0 | 0.0048 | 0.001 | 0.0029 | 0.0006 | 0.0008 | 0.0001 | 0.0008 | 0.0029 | 0.0008 | 0.0025 | 0.0005 | 0.0013 | 0.0005 | 0.0003 |
| Vacuole Periphery | 0.0009 | 0.0004 | 0.0001 | 0 | 0.0045 | 0.0006 | 0.0021 | 0.0002 | 0.0003 | 0 | 0.0007 | 0.0015 | 0.0003 | 0.0003 | 0.0002 | 0.0008 | 0.0005 | 0.0001 |
Sequencing Data
| R1 | R2 | |||||||||
|---|---|---|---|---|---|---|---|---|---|---|
| G1 Post-START | S/G2 | Metaphase | Anaphase | Telophase | G1 Post-START | S/G2 | Metaphase | Anaphase | Telophase | |
| Gene Expression | 40.1902 | 43.5486 | 40.3937 | 56.3494 | 36.318 | 73.0327 | 65.4975 | 79.4973 | 82.9939 | 45.1947 |
| Translational Efficiency | 2.6961 | 3.2405 | 2.8705 | 2.817 | 2.8977 | 2.3595 | 1.9798 | 2.6601 | 2.4948 | 2.3111 |
Hit Data
| Dataset | Hit |
|---|---|
| Protein Concentration | ✘ |
| Protein Localization | ✘ |
| Gene Expression | ✘ |
| Translational Efficiency | ✘ |
Endocytosis
| Temp | Actin Patch (Sac6-tdTomato) | Cortical Patch (Sla1-GFP) | Late Endosome (Snf7-GFP) | Vacuole (Vph1-GFP) |
|---|---|---|---|---|
| 37℃ | ||||
| RT |
Cell Cycle Omics
CYCLoPs (Tmc1-GFP)
| Gene / Allele | Actin Patch (Sac6-tdTomato) | Cortical Patch (Sla1-GFP) | Late Endosome (Snf7-GFP) | Vacuole (Sac6-tdTomato) |
|---|
| Gene | Images |
|---|
| Gene | Images |
|---|
Images are not yet available
Images are not yet available